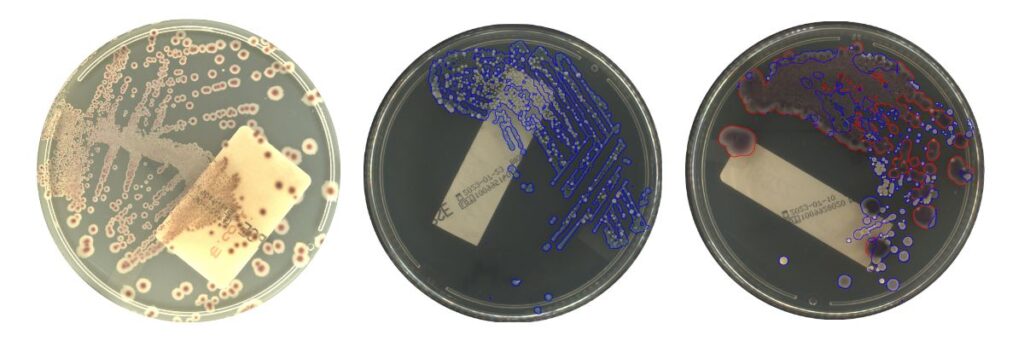

- Diagnóstico
Categorías:
Los módulos de incubación y digitalización microbiológica de Ai5 Lab de Sener ha irrumpido en el mercado de la microbiología con una innovación sin precedentes. Este sistema presenta, respaldada por un concepto de hardware disruptivo, una combinación de dos tecnologías de imagen que, al integrarse, prometen transformar la gestión de muestras en los laboratorios microbiológicos. La capacidad de ofrecer tanto un sistema de imagen tradicional como un sistema de monitorización continua en tiempo real marca un avance significativo en la eficiencia y precisión del diagnóstico.
Esta combinación de tecnologías representa una mejora sustancial en el manejo de muestras y la obtención de resultados en menor tiempo.
Protocolo basado en tiempo
El primer componente del Ai5 Lab es su sistema de imagen y algoritmos de inteligencia artificial basados en los protocolos de tiempo. Este sistema opera de manera tradicional, capturando imágenes de las muestras según intervalos de tiempo preestablecidos. Este método permite el análisis del crecimiento de microorganismos en las muestras conforme a los estándares convencionales de los laboratorios. La rutina de captura de imágenes en tiempos específicos facilita la documentación y seguimiento del desarrollo de las muestras a lo largo del tiempo.
Además, este enfoque permite una comparación detallada entre diferentes muestras y condiciones experimentales, lo que es esencial para la investigación y el diagnóstico preciso. Los intervalos de tiempo pueden ajustarse según las necesidades específicas del laboratorio, proporcionando flexibilidad y adaptabilidad a diversos tipos de muestras y estudios. Este sistema probado y fiable asegura que se mantenga un registro detallado y sistemático del crecimiento microbiano, lo que es crucial para la reproducibilidad de los experimentos y la validación de resultados. En última instancia, este sistema de imagen basado en el protocolo de tiempo es una herramienta indispensable para cualquier laboratorio de microbiología que busque mantener altos estándares de precisión y eficiencia en su trabajo diario.
Protocolo basado en crecimiento
El segundo componente, denominado sistema de monitorización continua, introduce una tecnología revolucionaria que redefine la manera en que se observa el crecimiento de las muestras en un laboratorio de microbiología. Este sistema permite observar el desarrollo de las muestras en tiempo real, sin la necesidad de abrir la incubadora o tocar las muestras, lo cual minimiza el riesgo de contaminación y preserva la integridad de las muestras. La monitorización continua proporciona un flujo constante de datos sobre el desarrollo de las muestras, permitiendo detectar cambios y patrones de crecimiento de manera inmediata y precisa.
Además, este sistema avanzado puede generar alarmas automáticas basadas en los datos recogidos, ayudando al personal del laboratorio a gestionar y priorizar las muestras según la urgencia del diagnóstico. Por ejemplo, si se detecta un crecimiento rápido o inusual en una muestra, el sistema puede alertar automáticamente al personal, permitiéndoles tomar decisiones informadas y actuar rápidamente. La capacidad de intervenir de manera rápida en respuesta a estas alarmas es crucial para el manejo eficiente de las muestras, especialmente en situaciones donde el tiempo es un factor crítico.


Este sistema también permite una mayor flexibilidad en el diseño de experimentos y la realización de estudios longitudinales, ya que proporciona un seguimiento continuo sin interrupciones. La información detallada y en tiempo real sobre el crecimiento de las muestras no solo mejora la precisión del diagnóstico, sino que también optimiza el uso de recursos del laboratorio al permitir una planificación más eficiente y una respuesta más rápida a las necesidades emergentes.
En resumen, el sistema de monitorización continua del Ai5 Lab representa un avance significativo en la tecnología de laboratorio, mejorando tanto la eficiencia operativa como la precisión en el diagnóstico microbiológico.
Protocolo Dual
La combinación de ambos sistemas de imagen en el nuevo sistema Ai5 Lab ofrece un protocolo dual que aprovecha lo mejor de ambos mundos, proporcionando una solución integral y versátil para los laboratorios de microbiología. Al utilizar avanzados algoritmos de inteligencia artificial, el sistema puede integrar los datos obtenidos de los dos métodos de imagen, acelerando considerablemente el proceso de análisis y mejorando la precisión del diagnóstico. Esta integración permite una evaluación más rápida y exhaustiva de las muestras, optimizando la gestión del laboratorio y potenciando la capacidad de respuesta ante situaciones críticas.
Además, la inteligencia artificial no solo acelera el procesamiento de datos, sino que también mejora la exactitud del análisis, reduciendo significativamente el margen de error humano. Este nivel de precisión y velocidad es crucial en entornos donde el tiempo y la exactitud son fundamentales para la salud del paciente. La combinación de estas tecnologías no solo optimiza los flujos de trabajo, sino que también libera tiempo valioso para los técnicos y científicos, permitiéndoles enfocarse en tareas más complejas y de mayor valor.
En definitiva, el protocolo dual del Ai5 Lab representa una evolución notable en la tecnología de diagnóstico microbiológico, ofreciendo una herramienta poderosa y eficiente que eleva los estándares de rendimiento en los laboratorios modernos.
Accelerate detection with
continuous monitoring system







